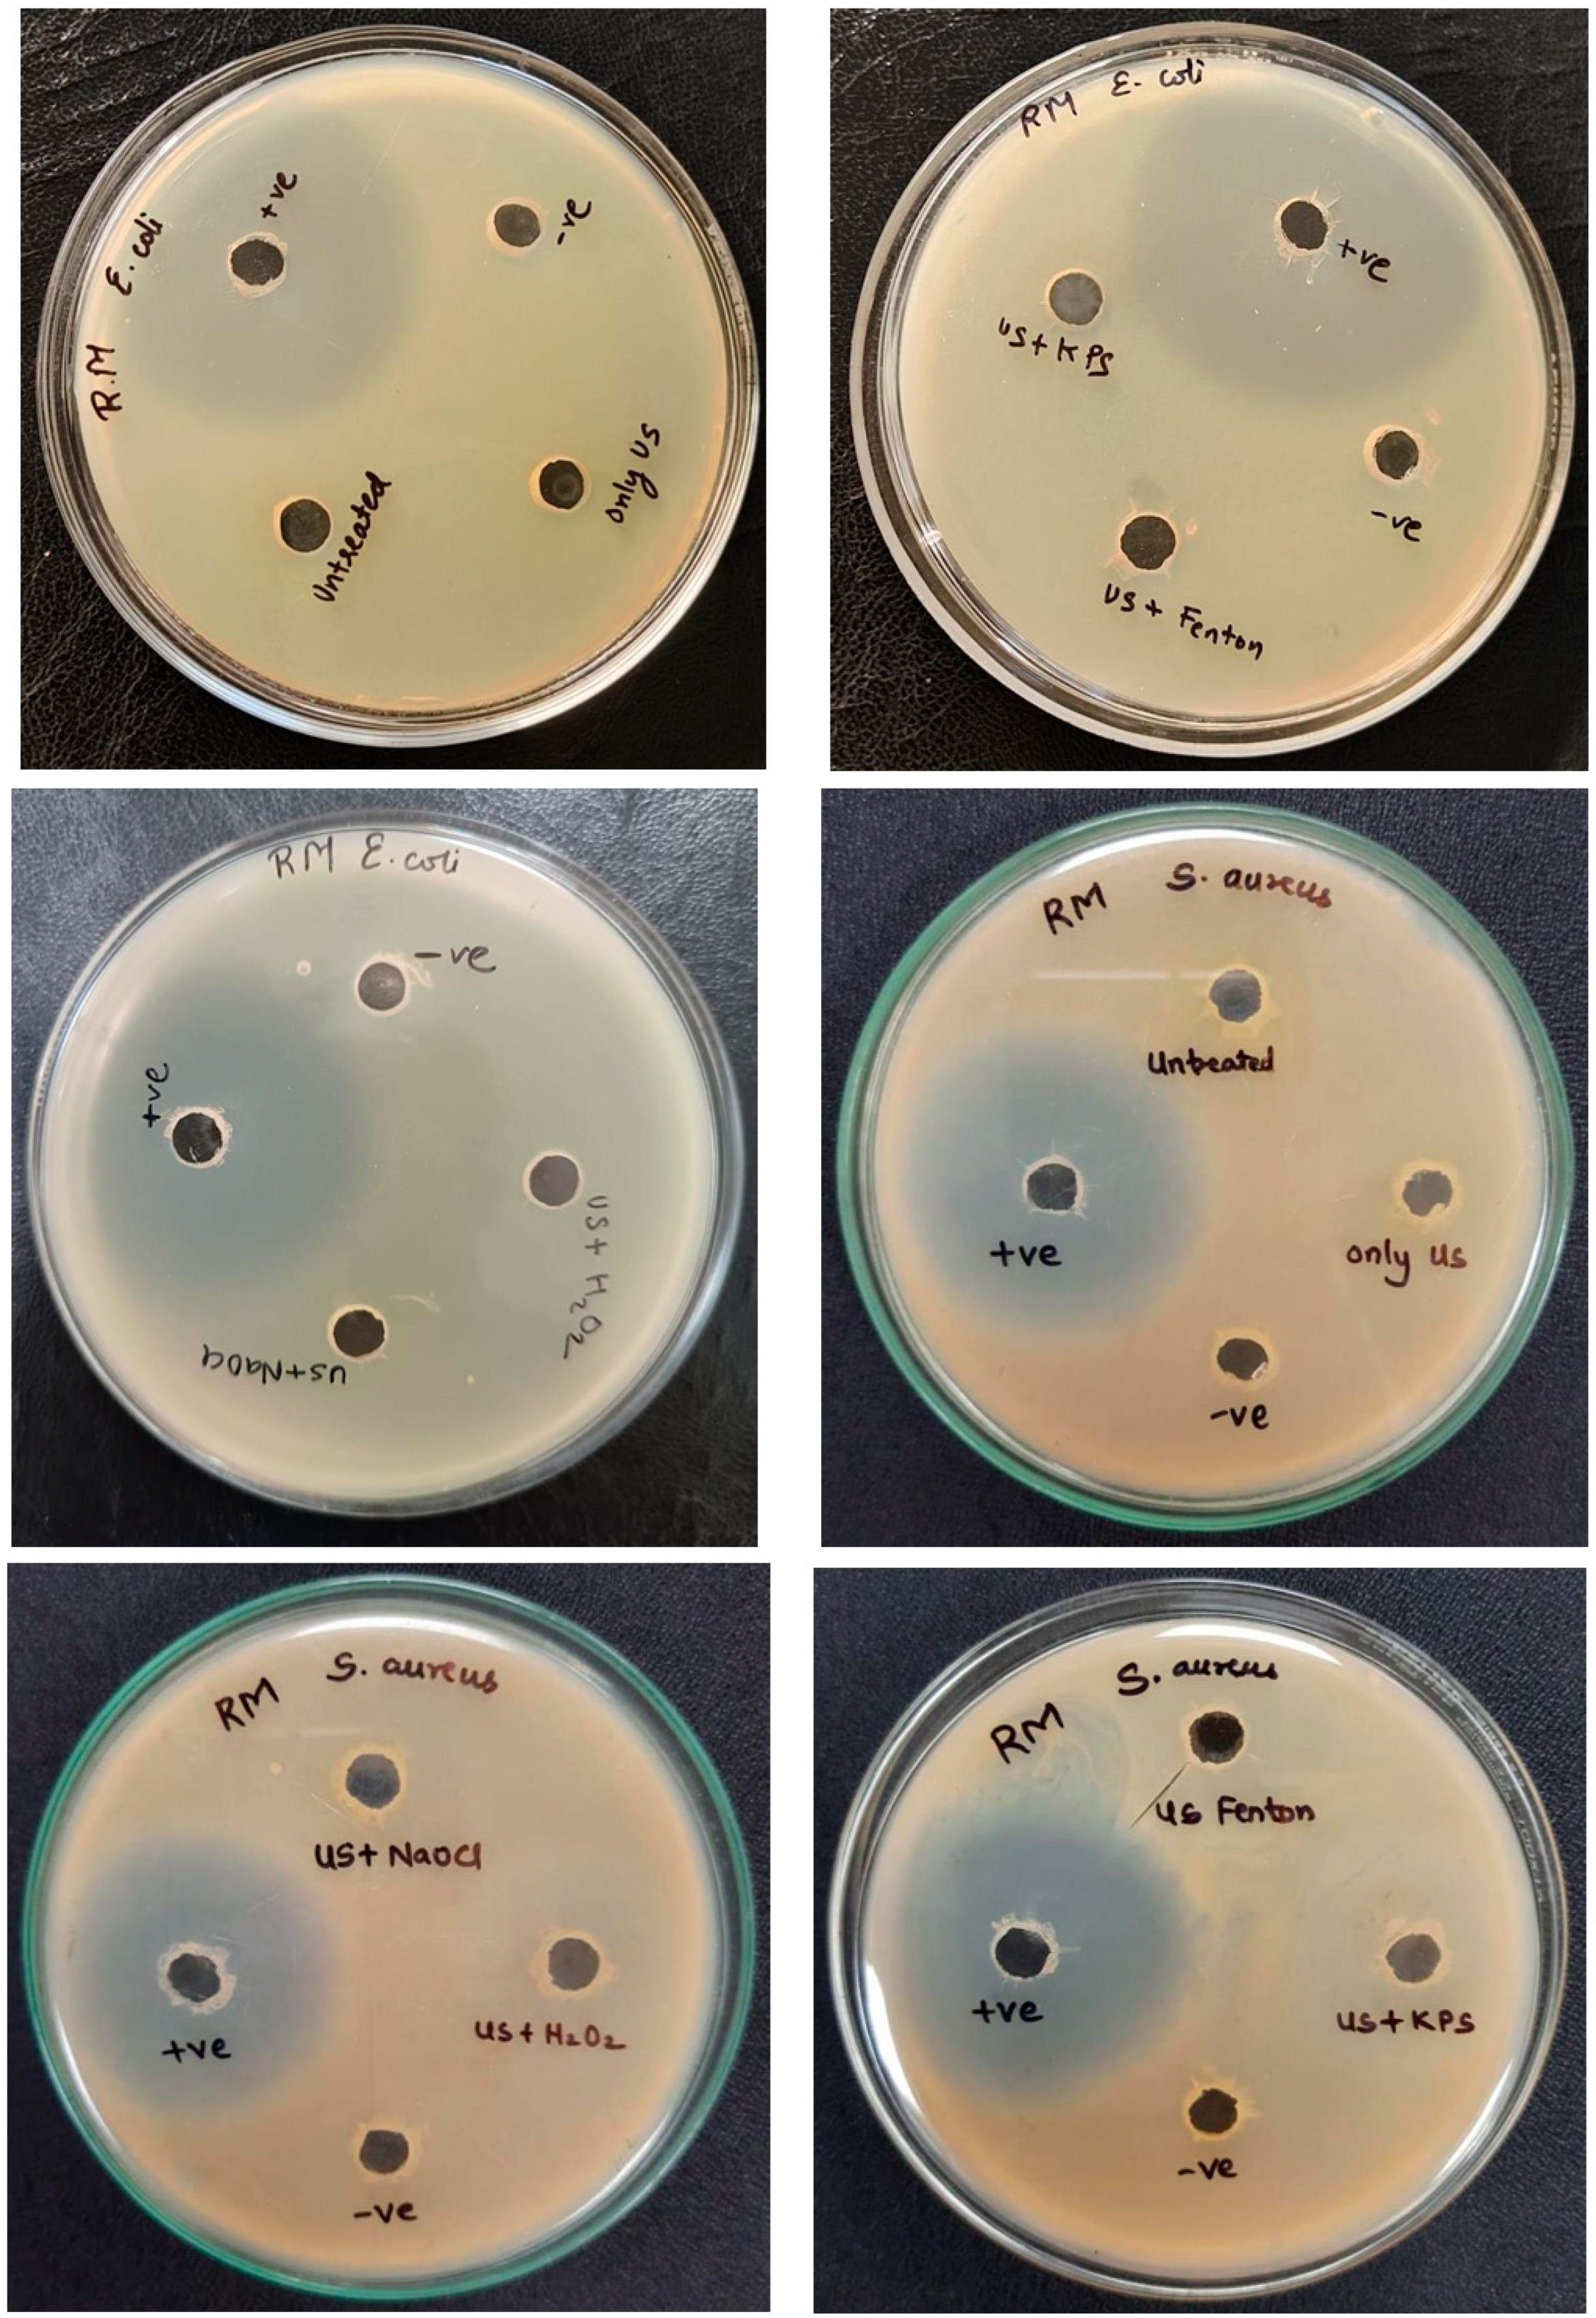
Water 16 02344 g011

Degradation of Procion Golden Yellow H-R Dye Using Ultrasound Combined with Advanced Oxidation Process
Abstract
1. Introduction
2. Materials and Methods
2.1. Materials
2.2. Experimental Methodology
2.3. Analysis
- = kinetic rate constant of ultrasonic cavitation in conjunction with the additive;
- = kinetic rate constant for only ultrasonic cavitation;
- = kinetic rate constant of only additive.
3. Results and Discussion
3.1. Effect of pH
3.2. Effect of Frequency
3.3. Effect of Power
3.4. Effect of H2O2 Loading in the Combination of Ultrasound with H2O2
3.5. Effect of the Fenton (H2O2/Fe2+) Reagent Ratio in the Combination of US + Fenton
3.6. Effect of NaOCl Loading in the Combination of US + NaOCl
3.7. Effect of KPS Loading in the Combination of US + KPS
3.8. Comparison of Mineralization Using Different Approaches
3.9. Toxicity Analysis
3.10. Cavitational Yield and Operating Cost for Different Treatment Approaches
4. Conclusions
Author Contributions
Funding
Data Availability Statement
Conflicts of Interest
References
- Chauhan, P.S.; Kumar, K.; Singh, K.; Bhattacharya, S. Fast Decolorization of Rhodamine-B Dye Using Novel V2O5-RGO Photocatalyst under Solar Irradiation. Synth. Met. 2022, 283, 116981. [Google Scholar] [CrossRef]
- Khan, S.A.; Manchanda, A.; Khan, T.A. Adsorption of Coomassie Brilliant Blue on a Novel Eco-Friendly Nanogel from Simulated Water: Equilibrium, Kinetic, and Thermodynamic Studies. ChemistrySelect 2024, 9, e202304927. [Google Scholar] [CrossRef]
- Lafi, W.K.; Al-Qodah, Z. Combined Advanced Oxidation and Biological Treatment Processes for the Removal of Pesticides from Aqueous Solutions. J. Hazard. Mater. 2006, 137, 489–497. [Google Scholar] [CrossRef]
- Askarniya, Z.; Sadeghi, M.T.; Baradaran, S. Decolorization of Congo Red via Hydrodynamic Cavitation in Combination with Fenton’s Reagent. Chem. Eng. Process.-Process Intensif. 2020, 150, 107874. [Google Scholar] [CrossRef]
- Zhang, X.; Qin, Y.; Zhang, W.; Zhang, Y.; Yuan, G.E. Oxidative Degradation of Orange G in Aqueous Solution by Persulfate Activated with Pyrite. Water Sci. Technol. 2020, 82, 185–193. [Google Scholar] [CrossRef]
- Cheng, M.; Zeng, G.; Huang, D.; Lai, C.; Xu, P.; Zhang, C.; Liu, Y. Hydroxyl Radicals Based Advanced Oxidation Processes (AOPs) for Remediation of Soils Contaminated with Organic Compounds: A Review. Chem. Eng. J. 2016, 284, 582–598. [Google Scholar] [CrossRef]
- Gogate, P.R. Cavitational Reactors for Process Intensification of Chemical Processing Applications: A Critical Review. Chem. Eng. Process. Process Intensif. 2008, 47, 515–527. [Google Scholar] [CrossRef]
- Siddique, M.; Farooq, R.; Price, G.J. Synergistic Effects of Combining Ultrasound with the Fenton Process in the Degradation of Reactive Blue 19. Ultrason. Sonochem. 2014, 21, 1206–1212. [Google Scholar] [CrossRef] [PubMed]
- Forgacs, E.; Cserháti, T.; Oros, G. Removal of Synthetic Dyes from Wastewaters: A Review. Environ. Int. 2004, 30, 953–971. [Google Scholar] [CrossRef] [PubMed]
- Naseer, A.; Nosheen, S.; Kiran, S.; Kamal, S.; Javaid, M.A.; Mustafa, M.; Tahir, A. Degradation and Detoxification of Navy Blue CBF Dye by Native Bacterial Communities: An Environmental Bioremedial Approach. Desalination Water Treat. 2016, 57, 24070–24082. [Google Scholar] [CrossRef]
- Lee, Y.H.; Pavlostathis, S.G. Decolorization and Toxicity of Reactive Anthraquinone Textile Dyes under Methanogenic Conditions. Water Res. 2004, 38, 1838–1852. [Google Scholar] [CrossRef]
- Guerra, W.N.A.; Santos, J.M.T.; De Araujo, L.R.R. Decolorization and Mineralization of Reactive Dyes by a Photocatalytic Process Using ZnO and UV Radiation. Water Sci. Technol. 2012, 66, 158–164. [Google Scholar] [CrossRef]
- Hassaan, M.A.; El Nemr, A.; Madkour, F.F.; Idris, A.M.; Said, T.O.; Sahlabji, T.; Alghamdi, M.M.; El-Zahhar, A.A. Advanced Oxidation of Acid Yellow 11 Dye; Detoxification and Degradation Mechanism. Toxin Rev. 2021, 40, 1472–1480. [Google Scholar] [CrossRef]
- Modirshahla, N.; Behnajady, M.A.; Ghanbary, F. Decolorization and Mineralization of C.I. Acid Yellow 23 by Fenton and Photo-Fenton Processes. Dye. Pigment. 2007, 73, 305–310. [Google Scholar] [CrossRef]
- Azzaz, A.A.; Assadi, A.A.; Jellali, S.; Bouzaza, A.; Wolbert, D.; Rtimi, S.; Bousselmi, L. Discoloration of Simulated Textile Effluent in Continuous Photoreactor Using Immobilized Titanium Dioxide: Effect of Zinc and Sodium Chloride. J. Photochem. Photobiol. A Chem. 2018, 358, 111–120. [Google Scholar] [CrossRef]
- Jaafarzadeh, N.; Takdastan, A.; Jorfi, S.; Ghanbari, F.; Ahmadi, M.; Barzegar, G. The Performance Study on Ultrasonic/Fe3O4/H2O2 for Degradation of Azo Dye and Real Textile Wastewater Treatment. J. Mol. Liq. 2018, 256, 462–470. [Google Scholar] [CrossRef]
- Behin, J.; Farhadian, N. Multi-Objective Optimization of Oxidative Desulfurization in a Sono-Photochemical Airlift Reactor. Ultrason. Sonochem. 2017, 38, 50–61. [Google Scholar] [CrossRef]
- Behin, J.; Farhadian, N. Response Surface Methodology for Ozonation of Trifluralin Using Advanced Oxidation Processes in an Airlift Photoreactor. Appl. Water Sci. 2017, 7, 3103–3112. [Google Scholar] [CrossRef]
- Momin, R.F.; Gogate, P.R. Degradation of Procion Brilliant Purple H-3R Using Ultrasound Coupled with Advanced Oxidation Processes. J. Environ. Manag. 2024, 350, 119642. [Google Scholar] [CrossRef]
- Momin, R.F.; Gogate, P.R. Degradation of Procion Brilliant Yellow H-E6G Using Ultrasonic and Hydrodynamic Cavitation Combined with Oxidants with Demonstration at Pilot Scale. Water Environ. Res. 2024, 96, e11011. [Google Scholar] [CrossRef]
- Lakshmi, N.J.; Agarkoti, C.; Gogate, P.R.; Pandit, A.B. Acoustic and Hydrodynamic cavitation-based combined treatment techniques for the treatment of industrial real effluent containing mainly pharmaceutical compounds. J. Environ. Chem. Eng. 2022, 10, 108349. [Google Scholar]
- Rajoriya, S.; Bargole, S.; Saharan, V.K. Degradation of a Cationic Dye (Rhodamine 6G) Using Hydrodynamic Cavitation Coupled with Other Oxidative Agents: Reaction Mechanism and Pathway. Ultrason. Sonochem. 2017, 34, 183–194. [Google Scholar] [CrossRef] [PubMed]
- Wang, J.; Guo, B.; Zhang, X.; Zhang, Z.; Han, J.; Wu, J. Sonocatalytic Degradation of Methyl Orange in the Presence of TiO 2 Catalysts and Catalytic Activity Comparison of Rutile and Anatase. Ultrason. Sonochem. 2005, 12, 331–337. [Google Scholar] [CrossRef] [PubMed]
- Zhang, H.; Zhang, J.; Zhang, C.; Liu, F.; Zhang, D. Degradation of C.I. Acid Orange 7 by the Advanced Fenton Process in Combination with Ultrasonic Irradiation. Ultrason. Sonochem. 2009, 16, 325–330. [Google Scholar] [CrossRef] [PubMed]
- Saharan, V.K.; Badve, M.P.; Pandit, A.B. Degradation of Reactive Red 120 Dye Using Hydrodynamic Cavitation. Chem. Eng. J. 2011, 178, 100–107. [Google Scholar] [CrossRef]
- Xu, D.; Ma, H. Degradation of Rhodamine B in Water by Ultrasound-Assisted TiO2 Photocatalysis. J. Clean. Prod. 2021, 313, 127758. [Google Scholar] [CrossRef]
- Alfonso-Muniozguren, P.; Serna-Galvis, E.A.; Bussemaker, M.; Torres-Palma, R.A.; Lee, J. A Review on Pharmaceuticals Removal from Waters by Single and Combined Biological, Membrane Filtration and Ultrasound Systems. Ultrason. Sonochem. 2021, 76, 105656. [Google Scholar] [CrossRef]
- Gote, Y.M.; Sinhmar, P.S.; Gogate, P.R. Sonocatalytic Degradation of Chrysoidine R Dye Using Ultrasonically Synthesized NiFe2O4 Catalyst. Catalysts 2023, 13, 597. [Google Scholar] [CrossRef]
- Neppolian, B.; Choi, H.C.; Sakthivel, S.; Arabindoo, B.; Murugesan, V. Solar/UV-Induced Photocatalytic Degradation of Three Commercial Textile Dyes. J. Hazard. Mater. 2002, 89, 303–317. [Google Scholar] [CrossRef] [PubMed]
- Song, W.; Ravindran, V.; Pirbazari, M. Process Optimization Using a Kinetic Model for the Ultraviolet Radiation-Hydrogen Peroxide Decomposition of Natural and Synthetic Organic Compounds in Groundwater. Chem. Eng. Sci. 2008, 63, 3249–3270. [Google Scholar] [CrossRef]
- Lu, Y.; Liu, Y.; Xia, B.; Zuo, W. Phenol Oxidation by Combined Cavitation Water Jet and Hydrogen Peroxide. Chin. J. Chem. Eng. 2012, 20, 760–767. [Google Scholar] [CrossRef]
- Merouani, S.; Hamdaoui, O.; Saoudi, F.; Chiha, M. Sonochemical Degradation of Rhodamine B in Aqueous Phase: Effects of Additives. Chem. Eng. J. 2010, 158, 550–557. [Google Scholar] [CrossRef]
- Kuo, W.G. Decolorizing Dye Wastewater with Fenton’s Reagent. Water Res. 1992, 26, 881–886. [Google Scholar] [CrossRef]
- Ma, Y.S.; Sung, C.F.; Lin, J.G. Degradation of Carbofuran in Aqueous Solution by Ultrasound and Fenton Processes: Effect of System Parameters and Kinetic Study. J. Hazard. Mater. 2010, 178, 320–325. [Google Scholar] [CrossRef]
- Joseph, J.M.; Destaillats, H.; Hung, H.M.; Hoffmann, M.R. The Sonochemical Degradation of Azobenzene and Related Azo Dyes: Rate Enhancements via Fenton’s Reactions. J. Phys. Chem. A 2000, 104, 301–307. [Google Scholar] [CrossRef]
- Harichandran, G.; Prasad, S. SonoFenton Degradation of an Azo Dye, Direct Red. Ultrason. Sonochem. 2016, 29, 178–185. [Google Scholar] [CrossRef]
- Song, Y.L.; Li, J.T.; Chen, H. Degradation of C.I. Acid Red 88 Aqueous Solution by Combination of Fenton’s Reagent and Ultrasound Irradiation. J. Chem. Technol. Biotechnol. 2009, 84, 578–583. [Google Scholar] [CrossRef]
- Joyce Tiong, T.; Price, G.J. Ultrasound Promoted Reaction of Rhodamine B with Sodium Hypochlorite Using Sonochemical and Dental Ultrasonic Instruments. Ultrason. Sonochem. 2012, 19, 358–364. [Google Scholar] [CrossRef][Green Version]
- Gogate, P.R.; Bhosale, G.S. Comparison of Effectiveness of Acoustic and Hydrodynamic Cavitation in Combined Treatment Schemes for Degradation of Dye Wastewaters. Chem. Eng. Process. Process Intensif. 2013, 71, 59–69. [Google Scholar] [CrossRef]
- Patil, N.N.; Shukla, S.R. Degradation of Reactive Yellow 145 Dye by Persulfate Using Microwave and Conventional Heating. J. Water Process Eng. 2015, 7, 314–327. [Google Scholar] [CrossRef]
- Momin, R.F.; Gogate, P.R. Degradation of Reactive Violet 1 Using Innovative Approach of Hydrodynamic Cavitation Coupled with Oxidants. Chem. Eng. Sci. 2024, 298, 120414. [Google Scholar] [CrossRef]

| Parameter | Values |
|---|---|
| Synonyms | Reactive Orange 12, Reactive Golden Yellow H-R |
| Molecular weight | 739 |
| Molecular formula | C21H14ClN8Na3O10S3 |
| Absorption maxima | 420 nm |
| Processes | Extent of Decolorization (%) | Extent of Mineralization (COD Reduction %) | First Order | |
|---|---|---|---|---|
| k (min−1) | R2 | |||
| Only US | 23.8 | 7.8 | 1.40 × 10−3 | 0.969 |
| US + H2O2 | 53.3 | 17.8 | 4.00 × 10−3 | 0.98 |
| US + Fenton | 94.6 | 29.6 | 8.97 × 10−2 | 0.982 |
| US + KPS | 97.5 | 34.4 | 2.06 × 10−2 | 0.991 |
| US + NaOCl | 90 | 25.8 | 1.21 × 10−2 | 0.988 |
| Zone of Inhibition in mm | |||||||||
|---|---|---|---|---|---|---|---|---|---|
| Sr No. | Organism | Untreated | Only US | US + H2O2 | US + Fenton | US + NaOCl | US + KPS | Positive Control | Negative Control |
| 1. | E. coli | - | - | - | - | - | - | 40 | - |
| 2. | S. aureus | - | - | - | - | - | - | 28 | - |
| Scheme | Extent of Decolorization (%) | Cavitational Yield (mg/J) | Energy Required (kWh) | Total Operational Cost (INR/L) |
|---|---|---|---|---|
| Only US | 23.8 | 1.10 × 10−5 | 6.30 × 10−1 | 5.34 |
| US + H2O2 | 53.3 | 2.47 × 10−5 | 2.81 × 10−1 | 2.89 |
| US + Fenton | 94.6 | 2.63 × 10−4 | 2.64 × 10−2 | 0.75 |
| US + KPS | 97.5 | 4.51 × 10−5 | 1.54 × 10−1 | 4.68 |
| US + NaOCl | 90 | 4.17 × 10−5 | 1.67 × 10−1 | 1.44 |
Disclaimer/Publisher’s Note: The statements, opinions and data contained in all publications are solely those of the individual author(s) and contributor(s) and not of MDPI and/or the editor(s). MDPI and/or the editor(s) disclaim responsibility for any injury to people or property resulting from any ideas, methods, instructions or products referred to in the content. |
© 2024 by the authors. Licensee MDPI, Basel, Switzerland. This article is an open access article distributed under the terms and conditions of the Creative Commons Attribution (CC BY) license (https://creativecommons.org/licenses/by/4.0/).
Share and Cite
Momin, R.F.; Deshmukh, K.R.; Gogate, P.R. Degradation of Procion Golden Yellow H-R Dye Using Ultrasound Combined with Advanced Oxidation Process. Water 2024, 16, 2344. https://doi.org/10.3390/w16162344
Momin RF, Deshmukh KR, Gogate PR. Degradation of Procion Golden Yellow H-R Dye Using Ultrasound Combined with Advanced Oxidation Process. Water. 2024; 16(16):2344. https://doi.org/10.3390/w16162344
Chicago/Turabian StyleMomin, Rahat F., Kalyani R. Deshmukh, and Parag R. Gogate. 2024. "Degradation of Procion Golden Yellow H-R Dye Using Ultrasound Combined with Advanced Oxidation Process" Water 16, no. 16: 2344. https://doi.org/10.3390/w16162344
APA StyleMomin, R. F., Deshmukh, K. R., & Gogate, P. R. (2024). Degradation of Procion Golden Yellow H-R Dye Using Ultrasound Combined with Advanced Oxidation Process. Water, 16(16), 2344. https://doi.org/10.3390/w16162344

